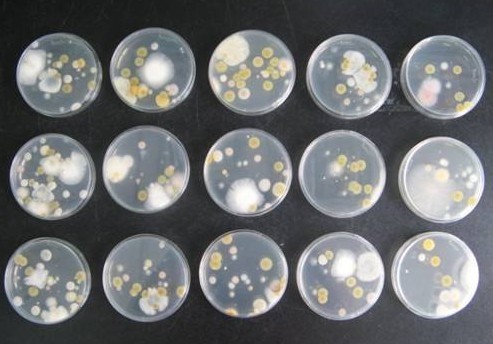
土壤微生物_360百科

诺卡氏放线菌混培而
1401x914 - 158KB - JPEG

单菌落
902x667 - 57KB - JPEG

放线菌
1157x595 - 111KB - JPEG

弗兰克氏菌属_360百科
250x220 - 12KB - JPEG

【健康】抗菌药≠抗生素≠消炎药!知道这些,你
310x232 - 7KB - JPEG

放线菌勇闯无重力空间
400x345 - 116KB - JPEG

3d贴图|3d材质
650x651 - 101KB - JPEG

放线菌属
400x265 - 7KB - JPEG

奇妙的人体寄居客(组图)-寄生
450x354 - 28KB - JPEG

神八装载样品33种 开展了17项空间生命科学实
470x408 - 82KB - JPEG

奇妙的土壤微生物
500x363 - 101KB - JPEG

土壤酸化问题愈加严重影响蔬菜大棚产量
1024x768 - 245KB - JPEG

放线菌属
220x165 - 6KB - JPEG
土壤微生物_360百科
493x344 - 41KB - JPEG

土壤微生物的大作用
300x270 - 36KB - JPEG
放线菌,是一类主要呈菌丝状生长和以孢子繁殖的陆生性较强大的原核生物。因在固体培养基上呈辐射状生长而
参考答案:真菌属低等植物,种类繁多,形态、大小各异,包括酵母菌、霉菌及各种伞菌。酵母菌处理和有机固体
3.绘制“链霉菌”的个体形态图。4.放线菌的菌丝有放线菌的菌落常呈辐射状而得名,菌落周缘有辐射形菌 丝。
在线互动式文档分享平台,在这里,您可以和千万网友分享自己手中的文档,全文阅读其他用户的文档,同时,也
霉菌的菌落呈圆形绒毛状、絮状或蜘蛛网状。放线菌的菌落是由一个分生孢子或一段营养菌丝生长繁殖引起许多
霉菌的菌落都比较大,有明显的菌丝体。产孢子的霉菌菌落上还有孢子。简单通俗点说,放线菌菌落呈防线状,
酵母菌的菌落类似于:()A.霉菌菌落 B.链霉菌菌落 C.细菌菌落 D.放线菌菌落
细菌 放线菌是原核酵母菌 霉菌是真核在菌落形态上,放线菌与霉菌相似细菌与霉菌的菌落有浓厚的毛茸茸的菌丝,
放线菌因菌落呈放线状而的得名,因此第一空应填霉菌 酵母菌菌落呈现圆形隆起,湿润,边界清晰,色泽乳白或其他,